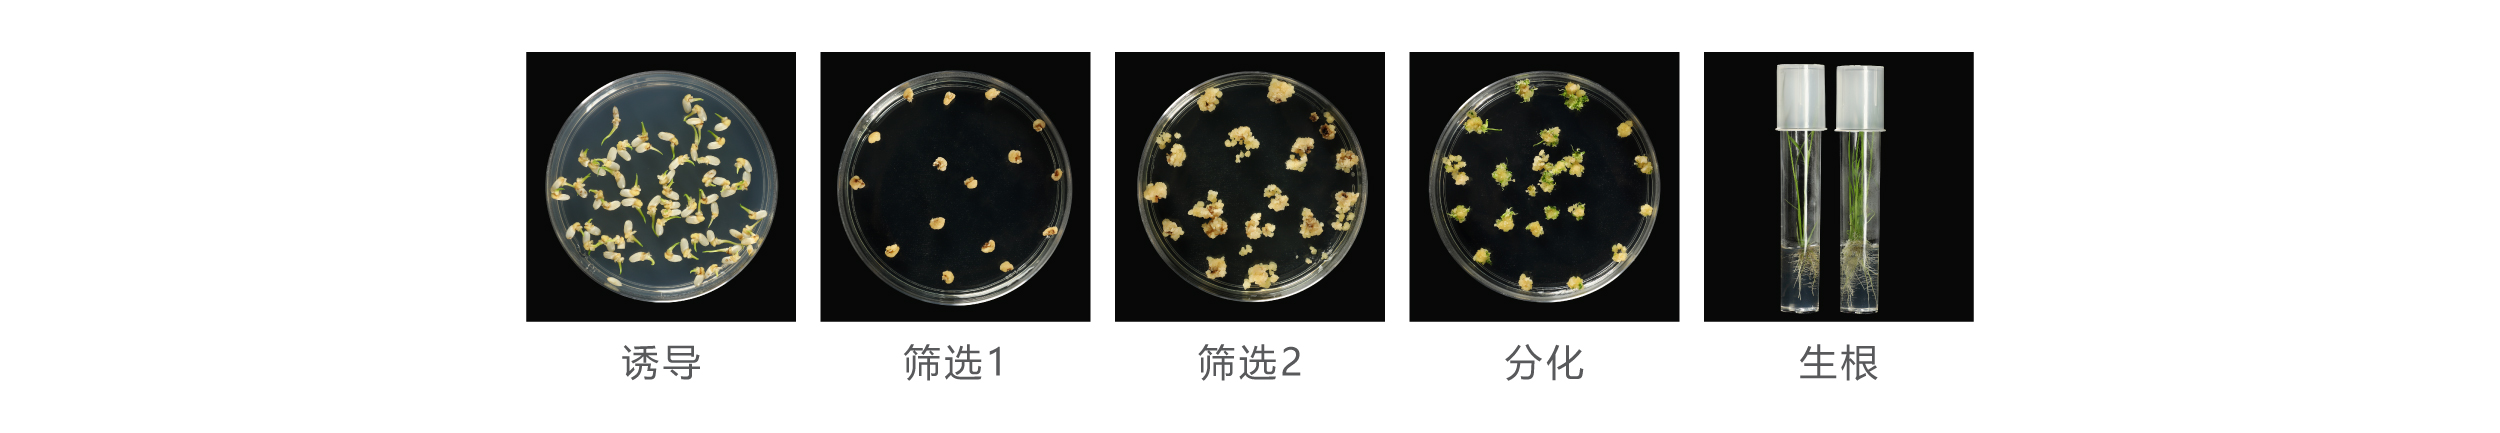
水稻

-
-
优势特点
(1)粳稻、籼稻、野生稻,且不受品种限制;
(2)基因编辑:多基因敲除(20个以上),编辑率达90%,其中纯合率达50%;
(3)80000+个载体的水稻基因编辑和遗传转化经验。
服务流程及周期
(1)服务流程:材料和信息接收、确认——实验方案设计、载体构建——遗传转化——结果鉴定——转基因植株邮寄;
(2)周期:2-3个月。
实验结果
(1)粳稻提供≥10株基因编辑苗,籼稻提供≥5株基因编辑苗;
(2)粳稻提供≥20株阳性苗:籼稻提供≥10株阳性苗(非基因编辑载体)。
-
|
水稻
|
